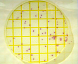

Контактные экспресс-тесты предназначены для проведения санитарного контроля на производствах, торговых предприятиях и организациях общественного питания методами отпечатка и взятия смывов с рабочих поверхностей, оборудования, рук персонала и воды, а также для оценки качества дезинфекции.
Контроль поверхности:
Для микробиологического контроля производственных поверхностей используется набор, который состоит из пластмассового держателя и тампона во флаконе со стерильным буфером. Тампоном берут смыв с поверхности, затем помещают тампон обратно во флакон с буфером и встряхивают несколько раз, перенося, таким образом, микрофлору с тампона в буфер. После этого в этот раствор помещают держатель на 30 секунд. За это время подложка впитывает 1 мл жидкости. Остаток буфера выливают, а держатель во флаконе помещают в термостат и инкубируют фильтром вниз.
Экспресс-тесты обеспечивают:
- определение ОМЧ через:
- 48 ч при 35 °С ;
- 72 ч при 25 °С;
- 7 суток при комнатной температуре;
- определение энтеробактерий через 24 ч при 35 °С;
- определение дрожжей/грибов через 48 ч при 32 °С или 72 ч при 28 °С.